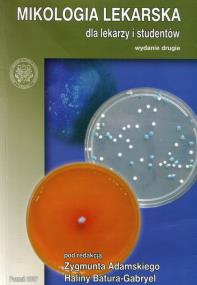
Opakowanie Mikologia lekarska dla lekarzy i studentów

Kategorie
|
|
Mikologia lekarska dla lekarzy i studentówNie ma jeszcze oceny, możesz być pierwszym, który ocenił!
Wydawca:
ISBN:
9788360187760
EAN:
9788360187760
Oprawa:
Miękka
Język:
polski
Format:
16.5x24.0cm
Liczba stron:
396
Rok wydania:
2007
wysyłka:
niedostępny
73,03
zł
Cena detaliczna:
80,00 zł
Produkt niedostępny
Najniższa cena z ostatnich 30 dni: 73,03 zł
Czynniki predysponujące do zakażeń grzybiczych i patomechanizm zakażeń grzybiczych
Zakażenia dermatofitowe
Grzybice odzwierzęce, podskórne, paznokci, endemiczne, przewodu pokarmowego, nerwowego, dolnych dróg oddechowych
Pneumocystoza
Zakażenia grzybicze w ginekologii i położnictwie
Zakażenia grzybicze oka
Diagnostyka mikologiczna
Leki stosowane w leczeniu grzybic układowych
Brak recenzjix
Uwaga!!!
Ten produkt jest zapowiedzią. Realizacja Twojego zamówienia ulegnie przez to wydłużeniu do czasu premiery tej pozycji. Czy chcesz dodać ten produkt do koszyka?
TAK
NIE


Wybierz wariant produktu
|
|